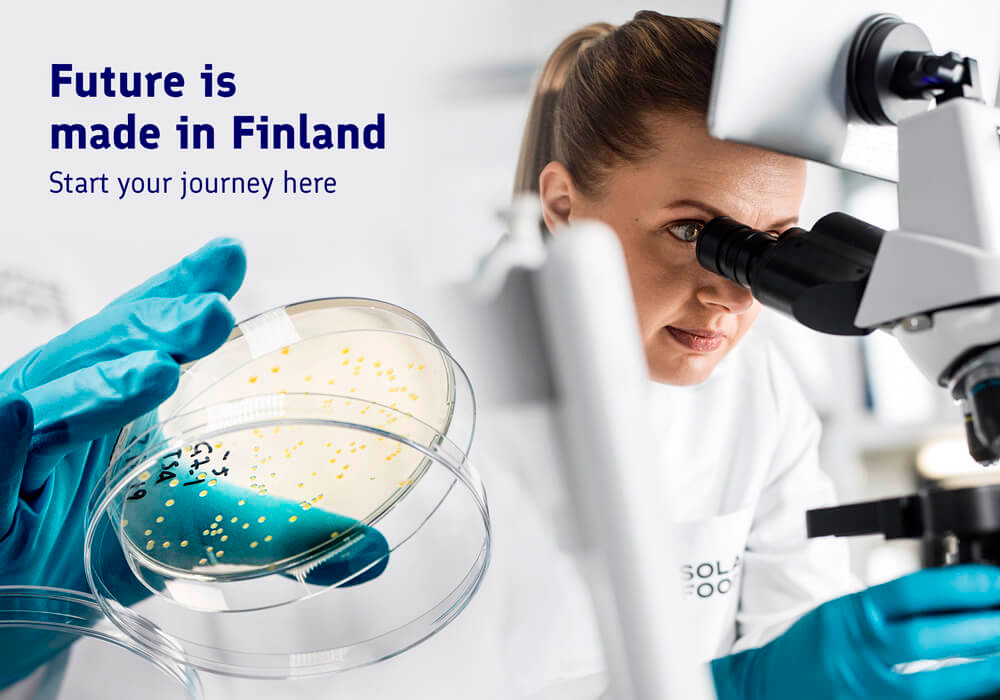

Future Crew es un grupo finés que creaba Demo-escenas para computadoras y software para las mismas, el grupo estuvo activo sobre todo en 1987 y 1994.
Historia
El grupo fue fundado en 1986 por PSI (Sami Tammilehto) y JPM (Jussi Markula) como un grupo de la Commodore 64, luego pasando al demoscene de las PC en 1988; otros miembros incluidos, con el tiempo, Trug, Wildfire, Pixel, ICE, GORE, Abyss, Purple Motion, y Skaven, así como varios otros no mencionados aquí.
Las demos más notables de Future Crew incluían Unreal (lanzada en la Assembly de 1992), Panic (lanzada en The Party de 1992) y Second Reality (lanzada en la Assembly de 1993). Second Reality es considerada como una de la demos de PC más influyentes que jamás se ha hecho.[1] Future Crew también es el responsable del tracker popular Scream Tracker, inspirado en otro software programado para la Amiga con el nombre de Soundtracker, así como el editor de sonido Advanced DigiPlayer y así se convirtió en inspiración de otros trackers como el Impulse Tracker.[2][3][4]
Premios y tributos
Una votación en el portal de noticias tecnológicas Slashdot eligió la demo Second Reality de Future Crew como uno de los "Mejores 10 Hacks de todos los tiempos", junto a hitos de la tecnología como el vehículo Mars Pathfinder, el computador Apple II o la misión de rescate del Apollo 13.[1] Entre los tributos al grupo Future Crew se encuentra el benchmark de gráficos 3D llamado Final Reality escrito por Remedy Entertainment en 1997, y una versión de "Second Reality" llamado Second Reality 64 desarrollado por Smash Designs para el Commodore 64. El sello discográfico Nectarine Records publicó un álbum tributo llamado "Metropolis" con las canciones más conocidas de Future Crew remasterizadas en 24-bit, que puede descargarse grátis.[5]
Miembros
Estos son los miembros del grupo en el momento del lanzamiento Second Reality:
- Gore (Samuli Syvähuoko): organizador
- Psi (Sami Tammilehto): programador
- Trug (Mika Tuomi): programador
- Wildfire (Arto Vuori): programador
- Purple Motion (Jonne Valtonen): música [1]
- Skaven (Peter Hajba): música y gráficos [2]
- Marvel (Aki Raula, formalmente Aki Määttä): artista gráfico
- Pixel (Misko Iho) : artista gráfico
- Abyss (Jussi Laakkonen): coordinador BBS / relaciones públicas
- Henchman (Markus Mäki): operador BBS
- Jake (Jarkko Heinonen): Internet PR
Lanzamientos
Future Crew lanzó las siguientes producciones en demoscene's para PC :
- GR8 (1988, demo)
- YO! (1989, demo)
- Slideshow I (1990, diapositivas)
- Scream Tracker 2 (1990, herramienta)
- Mental Surgery (1991, demo)
- Assembly '92 Invitation, aka. Fishtro (1992, invitación)
- Unreal (1992, demo, 1.º en Assembly 92)
- Starport BBStro (1992, BBStro)
- The Party 92 Invite (1992, invitación)
- Panic (1992, demo, 2.º en The Party 92)
- Assembly '93 Invitation (1993, invitación)
- Worldcharts #01 (1993, diskmag)
- Second Reality (1993, 1.º en Assembly 93)
- Bussimatkaintro (1993, intro)
- Journey 1 (1993, disco de música)
- Journey 2 (1993, disco de música)
- Starport BBS Add 2 (1993, BBStro)
- Chaotic Mind (1994, disco de música)
- Assembly '94 Pre-invitation (1994, invitación)
- Assembly '94 Invitation (1994, invitación)
- Soppa (1994, demo de 64k)
- Scream Tracker 3 (1994, herramienta)
- Metropolis (2011, compilación)
Referencias